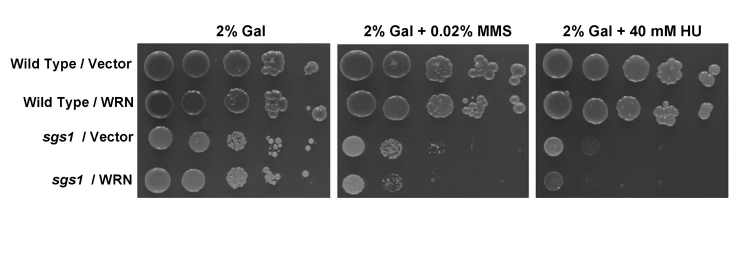

Introduction
Understanding the genetic pathways of the WRN helicase-exonuclease has posed a complex challenge to researchers. Studies of WRN-deficient cell lines have provided evidence for a role of WRN in the response to replicational stress through a recombinational repair pathway [1,2]; however, the precise molecular functions and protein interactions required for WRN to help cells proliferate, maintain genomic stability, and deal with endogenous or exogenously induced DNA damage are not well understood. Moreover, although the clinical and cellular phenotypes of Werner Syndrome (WS) appear to be distinct from that of the other human RecQ helicase disease, it is not clear if WRN has entirely unique or at least partially overlapping roles with the other RecQ helicases to maintain genomic stability (for review, see [3,4]).
To investigate the genetic functions of WRN in a defined setting, we have developed a yeast-based model system to study the functional requirements of WRN in pathways that are conserved between yeast and human. Unlike human cells which have five RecQ helicases (WRN, BLM, RECQ1, RECQ5, and RECQ4), Saccharomyces cerevisiae has only a single RecQ homolog, Sgs1 [4]. Although sgs1 mutants exhibit sensitivity to DNA damaging agents or replication inhibitors and display a shortened lifespan, the best known genetic function of sgs1 is to suppress the slow growth phenotype of a top3 mutant. It is believed that Top3 decatenates intertwined DNA molecules generated by Sgs1 helicase during replication [5,6]; therefore, in the absence of Top3, torsional stress is not relieved resulting in slow growth and hyper-recombination. Based on the genetic and physical interaction of Sgs1 with Top3 [5,7,8], a model has been proposed that together they suppress the formation of cross-over products that arise from the resolution of Holliday Junction (HJ) recombination intermediates [9,10]. Conserved interactions between RecQ helicases and Top3 exist in other organisms as well [11-15].
In human cells, BLM physically interacts with Top3α, and the two proteins together have the ability to catalyse double HJ dissolution on model DNA substrates in a reaction that requires BLM-mediated ATP hydrolysis and the active-site tyrosine residue of Top3α [16]. This reaction gave rise exclusively to non-cross-over products, as predicted from the hemicatenane model, and supports a proposed role of BLM with Top3α as a suppressor of sister chromatid exchanges (SCEs). RMI1 (BLAP75) promotes this BLM-dependent dissolution of the homologous recombination (HR) intermediate by recruiting Top3α to the double HJ [17,18]. Interestingly, BLM appears to be unique in the double HJ dissolution reaction since WRN, RECQ1 and RECQ5 all failed to substitute for BLM [17,19]. Moreover, association of Top3α and BLAP75 with BLM stimulates its HJ unwinding activity; however, neither WRN nor E. coli RecQ HJ unwinding was stimulated by Top3α BLAP75 [20]. Very recently, a new component of the BLM-Top3α complex, designated RMI2, was identified that is important for the stability of the BLM protein complex [21,22]. RMI2 deficiency in vertebrate cells results in chromosomal instability [21,22], suggesting its function as a tumor suppressor. RMI2 enhanced the double HJ dissolvase activity of the BLM-Top3α complex [21], indicating that additional proteins are likely to be involved. In fact, other proteins were isolated with the RMI2 complex, including the mismatch repair complex MSH2/6, RPA, and the Fanconi Anemia proteins FANCM and FAAP24 [21].
The suppression of recombinant cross-over products that are detected as sister chromatid exchanges is thought to be specific to the coordinate functions of yeast Sgs1 and Top3, and its human counterparts, BLM and Top3α However, RECQ5 and RECQ1 also interact with Top3α[23,24], and elevated SCE is also found in fibroblasts from RECQ5 [25] or RECQ1 [26] knockout mice as well as human cells depleted of RECQ1 by RNA interference [27]. These studies suggest that RecQ helicases participate in non-redundant pathways to suppress cross-overs during mitosis [28].
WS cells have a unique form of genomic instability known as variegated translocation mosaicism, characterized by extensive deletions and rearrangements [29]. WS cells, like other RecQ mutants, are also defective in recombination and sensitive to DNA damaging agents [3,30]. To begin to understand the basis for these defects in cellular DNA metabolism, we tested the ability of WRN in defined genetic backgrounds using yeast as a model system. Using this approach, we discovered that WRN restores the top3 slow growth phenotype in the sgs1 top3 background, but does not complement the DNA damage sensitivity or growth of a single sgs1 mutant. WRN helicase activity is required for genetic restoration of the top3 growth phenotype, suggesting that WRN unwinding activity creates a DNA substrate in vivo that in the absence of top3 prevents normal cell growth. These results have implications for the potentially overlapping pathways between RecQ helicases, particularly WRN and the human homolog of Sgs1, BLM. Moreover, depending on the genetic background, recombinational events initiated or mediated by WRN helicase activity may have consequences for cell cycle progression and cell growth.
Results
Expression of the human Werner syndrome protein (WRN) in yeast fails to rescue the methylmethanesulfonate or hydroxyurea hypersensitivity of an sgs1 mutant
The sgs1 strain is characterized by sensitivity to the compound methylmethanesulfonate (MMS), which introduces alkylation base damage or to hydroxyurea (HU), a replication inhibitor. To assess the effect of WRN expression on the MMS or HU-sensitivity phenotype of the sgs1 mutant, sgs1 was transformed with a multi-copy TRP1 selectable plasmid which is either empty or encoding full-length WRN protein (1-1432). Quantitative Western blot analyses using purified recombinant WRN protein as standard indicated that 8.1 x 104WRNmolecules/cell were present at 2% galactose (gal) concentration (data not shown). In comparison, the level of endogenous WRN in HeLa cells was determined to be 8.9 x 104 molecules/cell [31], in agreement with published values for WRN copy number in other human cells [32,33]. Therefore, the level of WRN protein expression in yeast is comparable to that in human cells and considered physiological. The sgs1 strain transformed with empty vector (sgs1/ /vector) did not expressprotein specifically recognized by WRN antibody (data not shown). Transformed sgs1 cells were serially diluted and spotted on to a synthetic complete (SC) 2% gal media lacking tryptophan (Trp) and containing the indicated concentration of either MMS or HU. As shown in Figure 1, WRN failed to rescue the sensitivity of the sgs1 mutant to MMS or HU, and was observed to enhance the sensitivity of sgs1 to either drug. The vector-transformed wild-type parent strain (W3031A) was included as a control, showing resistance to MMS or HU (Figure 1). The wild-type parent strain transformed with the YEp112SpGAL-WRN plasmid (Wild type/WRN) showed MMS and HU resistance comparable to Wild type/Vector (Figure 1), indicating that the drug sensitivity was dependent on the sgs1 mutation. Similar results were obtained at lower WRN protein levels induced by 0.5% gal (Supp. Data Figure 1).
Figure 1. WRN fails to rescue the MMS and HU sensitivity of sgs1. Cultures of wild-type
parental strain (W303-1A) or sgs1 strain transformed with
YEp112SpGAL or YEp112SpGAL-WRN were grown to early log phase (OD
600
of ~0.6 to 0.8). Ten-fold serial dilutions of these cultures were spotted
onto SC-Trp plates containing 2% gal and either MMS or HU at the indicated
concentrations. Plates were incubated at 30°C for 3 days (control plates)
and 5 days (MMS or HU plates) and then photographed.
WRN and TOP3 genetically interact
Strains mutant for top3 have pleiotropic phenotypes including severe growth defect, hyper-recombination at multiple loci, and sensitivity to the DNA damaging agents MMS and HU. However, a mutation in the sgs1 gene suppresses the slow growth rate of top3 [5]. Since it has been proposed that Top3 may be an evolutionarily conserved partner of RecQ helicases, we examined if the expression of WRN could substitute for Sgs1 and hence confer slow growth in the sgs1top3 background.
sgs1 top3 double mutant cells transformed with YEp112SpGAL or YEp112SpGAL-WRN were streaked onto plates containing SC minus Trp media with 2% gal. As shown in Figure 2A, the WRN transformed sgs1 top3 strain grew significantly slowly compared to the vector transformed sgs1 top3 strain. sgs1 top3 transformed with the YEp112SpGAL-SGS1 plasmid was included as a positive control (Figure 2A), demonstrating that wild-type Sgs1 expressed in the sgs1 top3 mutant was able to genetically complement the growth phenotype. The transformed sgs1 top3 strains grew similarly in the absence of gal as shown for 2 days (Figure 2A) or earlier time points (data not shown). Expression of WRN had no effect on the growth of parental wild-type (W3031A) or sgs1 strains (Figure 2B), indicating that the effect of WRN on cell growth was specific to that observed in the sgs1 top3 mutant background.
To further evaluate the effect of WRN expression on growth of the sgs1 top3 double mutant, liquid culture experiments were performed. After an initial lag phase for all cultures, sgs1 top3/WRN exhibited decreased growth compared to sgs1 top3/vector, evident at 12, 16, and 20 hr (Figure 2C). The decrease in cell growth for the sgs1 top3/WRN cells was not quite as great as that observed for sgs1 top3/SGS1, suggesting a partial restoration of the top3-associated growth phenotype by WRN.

Figure 2. WRN expression in sgs1 top3 restores the slow growth phenotype of top3. Panel A, sgs1 top3 strain transformed with YEp112SpGAL or YEp112SpGAL-WRN were
streaked on an SC-Trp plate containing either 2% glu or 2% gal. As a
control sgs1 top3 strain transformed with YEp112SpGAL-SGS1
was streaked on both the plates. Plates were incubated at 30°C for 2 days
and then photographed. Panel B, Wild type parental strain
W303-1A or sgs1 strain transformed with YEp112SpGAL or
YEp112SpGAL-WRN were streaked on an SC-Trp plate either containing 2% glu
or 2% gal. Plates were incubated at 30°C for 4 days and then
photographed. Composition of the plates was as in Panel A
and Panel B respectively. Panel C, Comparison
of growth of sgs1 top3 strain transformed with YEp112SpGAL,
YEp112SpGAL-WRN or YEp112SpGAL-SGS1. Logarithmically growing
cultures of above mentioned strains were reinoculated at OD0.05
in SC-Trp medium containing 2% gal and were incubated at 30°C. Growth of
the cultures was followed by their absorbance at OD600. The
experiment was repeated twice in duplicate with similar results. Data
represent the mean with standard deviations indicated by error bars.
WRN expression alters the cell cycle distribution of sgs1 top3
It was previously shown that top3 mutant strains are delayed in the late S/G2 phase of the cell cycle [5], a characteristic that may account for their slow growth. Mutation of the SGS1 gene in the top3 background suppresses the delay in the S/G2 phase of the cell cycle; consequently, the characteristic dumbbell shaped morphology of the top3 mutant yeast cells that have not completed cell division is suppressed by the sgs1 mutation. We examined if WRN expression could restore the delay in the S/G2 phase of the cell cycle in sgs1 top3. An elevated population of large budded cells with undivided nuclei was observed for the sgs1 top3 mutant cells expressing WRN (Figure 3). The percentage of sgs1 top3/WRN cells with dumbbell morphology was approximately 2.6-fold greater than that ofsgs1 top3/vector cells, suggesting that WRN expression in the sgs1 top3 mutant restored the characteristic S/G2 delay of top3 and this may contribute to the suppression of growth by WRN in the sgs1 top3 cells.

Figure 3. WRN expression induces S/G2 arrest in sgs1 top3 cells. Logarithmically growing
cultures of sgs1 top3 strain transformed with YEp112SpGAL, YEp112SpGAL-WRN,
or YEp112SpGAL-SGS1, and the vector-transformed wild-type parental strain
were induced at 2% gal concentration for 6 h. Cultures were harvested,
processed for DAPI staining as described in "Materials and Methods" and
were observed using Axiovert 200 M microscope(Zeiss; 100x lens). Shown is the DAPI staining of the sgs1
top3 transformed with YEp112SpGAL (upper left) and with YEp112SpGAL-WRN
(upper right). Arrows show cells with undivided nuclei. Distribution of
the cells in G1 (single cells) and S/G2 (budded cells) is shown in lower
panel.
WRN ATPase/ helicase but not exonuclease activity is required to restore the top3 slow growth phenotype
To assess the functional requirements of WRN to restore the slow growth phenotype in the sgs1 top3 background, we assessed the importance of WRN catalytic activities (helicase, exonuclease) for slow growth phenotype restoration. To do this, we constructed WRN expression plasmids containing missense point mutations in the active site of the conserved exonuclease domain (E84A) or the ATPase/helicase domain (K577M) that were previously shown to inactivate the respective catalytic activities of the purified recombinant proteins [34,35] (Figure 4A). Plasmids encoding the WRN mutant alleles were transformed into thesgs1 top3 cells and expression of the mutant WRN proteins was confirmed by Western blot analyses (Figure 4B). The effects of mutant WRN protein expression on growth were assessed by streaking the transformed yeast strains onto SC plates media with 2% gal but lacking Trp. Streak analysis revealed that the WRN-E84A exonuclease dead mutant restored the top3-associated slow growth phenotype in sgs1 top3 comparable to wild-type WRN, whereas the WRN-K577M ATPase/ helicase dead mutant failed to restore the slow growth in thesgs1 top3 as shown by its similar level of growth to that of the sgs1 top3/vector cells (Figure 4D). However, the sgs1 top3/WRN-E84A and sgs1 top3/WRN-K577M cells grew equally well in the absence of gal induction (Figure 4E). From these results, we conclude that WRN helicase but not exonuclease activity was required for restoration of slow growth phenotype characteristic of top3 in the sgs1 top3 background.

Figure 4. WRN ATPase/helicase, but not exonuclease activity, is required to restore the slow growth phenotype of top3 in sgs1 top3 background. Panel A, WRN
protein with conserved domains and positions of site-directed mutations. PanelB, Expression of WRN and WRN variants in transformed sgs1
top3 was induced at 2% gal concentration and cells were harvested after 6
h. Equal amount of total cell lysate was loaded on to 8-16% polyacrylamide
SDS gels, followed by Western blotting using anti-WRN antibody. sgs1 top3 strain
transformed with ATPase/helicase-dead (YEp195SpGAL-WRN K577M),
exonuclease-dead (YEp195SpGAL-WRN E84A), RQC mutant (YEp195SpGAL-WRN
K1016A), or polymorphic mutant (YEp195SpGAL-WRN R834C) was streaked on
SC-Trp plates containing either 2% glu (Panel E) or 2% gal (Panel
D). Plates were incubated at 30°C for 2 days and then
photographed. Composition of the plates was as in Panel C.
Genetic analysis of a naturally occurring WRN missense polymorphism or engineered RQC domain WRN missense mutant in the sgs1 top3 background
In addition to the helicase domain, many RecQ helicases share another conserved sequence C-terminal to the ATPase/helicase core domain designated the RecQ C-terminal (RQC) region that has been implicated in DNA binding and protein interactions [4]. To address the potential importance of the WRN RQC domain for its biological function, we examined the ability of a specific WRN RQC missense mutant, WRN-K1016A (Figure 4A), to restore the slow growth phenotype of top3 in sgs1 top3. The WRN-K1016A mutant was previously characterized and shown to have significantly reduced DNA binding and helicase activity compared to the wild-type recombinant WRN protein [36]. sgs1 top3 expressing WRN-K1016A (Figure 4B) grew similarly to the sgs1 top3/vector cells (Figure 4D), indicating that expression of the WRN-K1016A mutant failed to restore the slow growth phenotype characteristic of the top3 mutant.
Although no missense mutations have been identified that are genetically linked to Werner syndrome, a number of WRN polymorphic missense variants exist whose biological significance is not well understood. The lack of genetic data on WRN polymorphisms suggested to us that the yeast-based WRN system might be useful in their analysis. The WRN-834C polymorphism residing in the core helicase domain wasidentified in DNA from the Polymorphism Discovery Resource database (egp.gs.washington.edu) (Figure 4A). Previously, it was reported by the Loeb lab that the purified recombinant WRN-R834C protein has dramatically reduced WRN ATPase, helicase, and helicase-coupled exonuclease activity [37]. To assess the biological effect of the WRN R834C polymorphic change, sgs1 top3/WRN-R834C was streaked onto a SC plate lacking Trp and containing 2% gal. Expression of WRN-R834C (Figure 4B) demonstrated comparable growth to that of sgs1 top3/vector (Figure 4D). These results demonstrate that the WRN-R834C polymorphism, similar to the K577M and K1016A mutations that interfere with WRN helicase activity, interfere with WRN function in the sgs1top3 background.
Previous studieshave shown that gene expression levels from the GAL1/10 promotorcan be regulated by altering the concentration of gal in thegrowth medium. We therefore examined the level of WRN protein expression in cells grown at lower gal concentrations (0-2%) in the presence of 2% raffinose (raf). Western blot analyses demonstrated that WRN expression was dependent on the concentration of gal in the media (Figure 5A). Quantitative Western blot analyses using purified recombinant WRN protein as standard indicated that 2.3 x 104WRN molecules/cell were present at 2% gal. As WRN expression was regulated by the level of gal, we wanted to compare the ability of WRN and its associated variants to restore the slow growth phenotype of top3 in sgs1 top3 background at lower levels of protein expression. WRN restored the slow growth phenotype of sgs1 top3 throughout the gal concentration range, including the lower gal concentrations (Figure 5C-F). Similarly, WRN-E84A mutant restored the slow growth top3 phenotype, whereas the ATPase/ helicase dead WRN-K577M mutant failed to do so (Figure 5C-F). Likewise, neither WRN-R834C nor WRN-K1016A affected the growth of the sgs1 top3 mutant (Figure 5C-F). No effect on the growth rate of wild-type parental strain (W3031B) as well as sgs1 strain was observed with WRN or its associated variants (Supp. Data Figures 2 and 3). These results demonstrate that wild-type WRN or the WRN exonuclease dead proteins are similarly able to restore the top3 growth phenotype in the sgs1 top3 background, whereas the WRN mutant proteins that have defective ATPase/helicase activity did not affect the growth of the sgs1 top3 mutant at either low or high levels of gal-induced protein expression.

Figure 5. WRN mediated restoration of slow growth phenotype in sgs1 top3 background is independent of its expression level. WRN expression in the transformed sgs1 top3
cells was induced with the indicated gal concentrations and cells were
harvested 6 h after induction. As a control, sgs1 top3/YEp112SpGAL
was included. Equal amounts of total cell lysate were loaded on 8-16% polyacrylamide SDS gels followed by Western
blot detection using anti-WRN antibody as shown in PanelA.
sgs1 top3 strain transformed with YEp112SpGAL, YEp112SpGAL-WRN, exonuclease-dead
(YEp195SpGAL-WRN E84A), ATPase/helicase-dead (YEp195SpGAL-WRN K577M), RQC mutant (YEp195SpGAL-WRN K1016A),
polymorphic mutant(YEp195SpGAL-WRN R834C) and YEp112SpGAL-SGS1 was streaked on SC-Trp plate containing
gal at varying concentrations asindicated. Plates were incubated at 30°C for 2 days and then photographed.
Panels C-F show the effect of WRN expression onthe growth rate of sgs1 top3 transformed strains
at different gal concentrations. Composition of the plates was as in PanelB.
Effect of WRN expression on the MMS and HU sensitivity of the sgs1 top3 mutant
Previously, it was reported that the sgs1 top3 double mutant is less sensitive to MMS or HU than the top3 single mutant [6]. Since WRN affected cell growth of sgs1 top3, we next examined its effect on drug sensitivity. As shown in Figure 6, sgs1 top3/WRN displayed sensitivity to both MMS and HU that was comparable to sgs1 top3/SGS1, whereas sgs1 top3/vector was more resistant to either drug. Genetic analysis of the WRN variants in the sgs1 top3 background revealed that strains transformed with WRN-K577M, WRN-K1016A, or WRN-R834C displayed sensitivity comparable to that of vector, whereas the sgs1 top3/WRN-E84A strain showed HU and MMS resistance similar to sgs1 top/WRN and sgs1 top3/SGS1 (Figure 6). These results demonstrate that in addition to its effect on growth in the sgs1 top3 background, WRN also affects sensitivity of the sgs1 top3 mutant to HU or MMS. Furthermore, WRN ATPase/helicase but not exonuclease activity is genetically required for its effect on HU or MMS sensitivity in the sgs1 top3 background. Expression of WRN in the wild-type parent strain had no effect on the strain's sensitivity to the tested concentration of HU or MMS (Supp. Data Figure 4), indicating that the effect of WRN expression was dependent on the sgs1 top3 genetic background.

Figure 6. Effect of WRN expression on the MMS and HU sensitivity of sgs1 top3 strain. Logarithmically growing
cultures of sgs1 top3 strain transformed with YEp112SpGAL,
YEp112SpGAL-WRN, exonuclease-dead (YEp195SpGAL-WRN E84A),
ATPase/helicase-dead (YEp195SpGAL-WRN K577M), RQC mutant (YEp195SpGAL-WRN
K1016A), polymorphic mutant (YEp195SpGAL-WRN R834C), YEp112SpGAL-SGS1 and
vector transformed wild type parental strains were spotted in a ten-fold
serial dilutions onto SC-Trp plates containing glu or gal and either MMS or
HU at the indicated concentrations. Plates were incubated at 30°C for 2
days (control plates) and 4 days (MMS and HU plates) and then photographed.
Discussion
From our studies, we conclude that WRN genetically interacts with Top3 through its ability to restore the top3 slow growth phenotype in the sgs1 top3 background. WRN helicase activity is required for genetic restoration of slow growth, similar to previous studies which demonstrate that sgs1 helicase defective alleles fail to suppress top3 slow growth [38,39]. Although WRN suppressed the growth in the sgs1 top3 double mutant, WRN did not rescue the sensitivity of sgs1 to the DNA damaging agent MMS or the replication inhibitor HU. Thus, WRN cannot directly replace the Sgs1 helicase in the cellular response to replicational stress. However, in a pathway defined by genetic background, human WRN expressed in yeast can clearly exert a phenotype. The ability of WRN to affect the growth phenotype in the sgs1 top3 background is supported by our observation that the morphological appearance of large budded cells with undivided nuclei characteristic of S/G2 arrest is restored in the WRN-transformed sgs1 top3 mutant. This work is the first demonstration that WRN can function in a genetic pathway that affects top3-related phenotypes, and this role is dependent on WRN helicase but not exonuclease activity.
Previous studies demonstrated that expression of WRN or BLM in sgs1 does not affect growth rate, but can partially suppress illegitimate recombination or homologous recombination [40]. However, a distinction in the biological functions between the two human RecQ helicases was suggested based on the observation that expression of BLM, but not WRN, can restore the resistance of the sgs1 mutant to the replication inhibitor HU [40] and extend the shortened lifespan caused by the sgs1 mutation [41]. It was also reported that human BLM, but not WRN, can suppress the growth in the sgs1 top3 double mutant [40], suggesting that yeast Sgs1 helicase has functions similar to those of human BLM helicase. Although we also observed that WRN expression failed to correct the HU sensitivity of the sgs1 mutant, we found that WRN expression can restore the top3 slow growth phenotype in the sgs1 top3 background. The difference between our study and the earlier one may reflect differences in WRN protein expression (since the earlier study did not report a quantitative level of WRN protein), strains, or yeast culture conditions. Our quantitative Western blot analyses demonstrate that WRN expressed in yeast at levels comparable to that previously reported in several human cell lines was sufficient to restore growth in the sgs1 top3 mutant as detected by plate streak studies or liquid culture growth analysis. From these results, we conclude that WRN can function in the sgs1 top3 background, indicating some genetic overlap between the WRN and Sgs1 pathways. By inference, WRN may also have overlapping genetic functions with BLM. Although WRN was not observed in vitro to substitute in the BLM-Top3α complex double HJ dissolution reaction (see Introduction), it is plausible that WRN interacts with Top3α in a related protein complex with additional factors and can perform a function important for genomic stability. The results from our sgs1 top3 WRN complementation studies in yeast prompt further investigation of the possibility that WRN functionally interacts with Top3α in human cells during cellular DNA replication or recombination. Conceivably, in a BLM-impaired condition, WRN may partially substitute for BLM through its protein partnership with a topoisomerase.
In a previous study, we found that human WRN expressed in a yeast dna2-1 mutant background can rescue the associated replication and repair phenotypes; however, a non-catalytic C-terminal domain of WRN was sufficient for genetic rescue, demonstrating that WRN helicase activity is not required to rescue the mutant cellular phenotypes associated with the dna2-1 mutant [31]. Based on genetic and biochemical results, the explanation for this finding was that WRN rescues the dna2-1 mutant by interacting with endogenous yeast Flap Endonuclease-1 (FEN-1) and stimulating its nuclease activity, thereby bypassing the requirement for wild-type DNA2 nuclease to process DNA replication and repair intermediates [31,42]. In contrast, we show in the current study that WRN helicase activity is required to suppress growth in the sgs1 top3 mutant. The distinct genetic requirements for WRN to rescue different mutant backgrounds suggest that WRN can operate in separate pathways using different catalytic or protein interaction domains. We propose that WRN is a modular pleiotropic protein with unique catalytic or protein interaction domains that are necessary to fulfill its functions in different biological settings dictated by mutant genetic background.
In addition to the yeast studies which have examined the genetic interactions between sgs1 and top3, the potential functional overlap of Sgs1 with other topo-isomerases has been investigated. For example, sgs1 top1 mutants are severely growth impaired, suggesting that the synergistic defect can be attributed to the two genes operating in separate but overlapping pathways. This is distinct from the epistatic relationship of sgs1 and top3. Based on their genetic findings, Weinstein and Rothstein proposed that a subset of DNA structures which arise at stalled or collapsed replication forks normally processed by the Sgs1-Top3 pathway can be alternatively channeled into a Top1-dependent pathway in the absence of active Sgs1 helicase activity [39]. It is conceivable that WRN, which interacts physically and functionally with human TOP1 [43], may collaborate with Top1 (or another topoisomerase) in yeast to generate a viable but poorly growing cell in a pathway parallel to Sgs1. Alternatively, WRN may directly substitute for Sgs1 only in a specialized situation when Top3 is absent. It is conceivable that the poor growth of the top3 mutant is attributed to unresolved recombinogenic DNA intermediates created by WRN helicase activity. This last idea underscores a growing notion in the field that genetic recombination must be properly regulated; otherwise, deleterious recombination events acting on aberrant DNA structures prevail [44]. Thus, RecQ helicase-mediated recombination pathways are like a double-edged sword. In the appropriate genetic background, these pathways secure a normal growth rate and genomic stability; however, in certain mutant backgrounds (e.g., top3), DNA unwinding by a RecQ helicase is counter-productive to cell growth and genome homeostasis.
Materials and Methods
Plasmid DNA constructs. Site-directed mutations of WRN (E84A, K577M, R834C, and K1016A) in the plasmid YEp195SpGAL-WRN [31] were constructed using mutagenic primers (Supplementary Table 1) and a standard protocol from Quickchange II XL site-directed mutagenesis kit (Stratagene) by Lofstrand labs (Gaithersburg, MD). DNA fragments encoding WRN and its associated variants were gel purified from the respective YEp195SpGAL-WRN constructs after double digestion with SalI and MluI. Gel purified fragments were then cloned into the SalI-MluI sites of vector YEp112SpGAL [45], a 2 μm multi-copyplasmid containing a TRP1 selectable marker to construct YEp112SpGAL-WRNor WRN variants under the control ofa gal-inducible promotor. The SGS1 expression plasmid pSGS1f2 was kindly provided by Dr. Brad Johnson (University of Pennsylvania School of Medicine, Philadelphia, Pennsylvania). SGS1 was PCR amplified using 5'-ACGCGTCGACATGGTGACGAA GC-3' and 5'-GTCTCCTTCACTACGCGTCGAAT-3' as the forward and the reverse primers, respectively, using pSGS1f2 as a template. PCR was carried out with PCR super mix HiFi (Invitrogen) for 30 cycles (denaturation at 94°C for 30 s per cycle, annealing at 57°C for 50 s per cycle, and elongation at 72°C for 5 min per cycle). The amplified product was cloned into the SalI-MluI sites of vector YEp112SpGAL.
Yeast media and strains. Strains with wild-type SGS1 TOP3 (WT; W303-1A, genotype, MATa ade2-1 canl- 100 his3-11,15 leu2-3,112 trpl-l ura3-1) [5], a sgs1 mutant (W1292-3C; genotype MATa SUP4-o::URA3 sgs1-25 ade2-1 can1-100 his3-11,15 leu2-3,112 trp1-1 ura3-1 rad5-535) and a sgs1 top3 mutant ( W1058-11C, genotype, MATa SUP4-o::URA3 sgs1-25 top3-2::HIS3 ade2-1 can1-100 his3-11,15 leu2-3,112 trp1-1 ura3-1 rad5-535) have been characterized [6] and were kindly provided by Dr. Rodney Rothstein (Columbia University). Yeast cultures were grown using standard protocol and transformations were performed using a Lithium Acetate-based protocol [46]. Transformed yeast strains were grown in SC media minus Trp and containing either glucose (glu) or gal as required.
Genetic analysis of hydroxyurea or methylmethane-sulfonate sensitivity in WRN transformed yeast strains. To determine the effect of WRN expression on the MMS and HU sensitivity of sgs1 or sgs1 top3 strains, strains transformed with YEp112SpGAL or YEp112SpGAL-WRN were grown in SC raf minus Trp at 30oC. Cultures were reinoculated in SC raf minus Trp and grown at 30°C to early log phase (OD600 of ~0.6 to 0.8). Ten-fold serial dilutions of these strains were spotted onto SC gal minus Trp plates containing the indicated concentrations of HU or MMS. Plates were incubated at 30°C. As a control, wild-type parental strain (W303-1A) transformed with YEp112SpGAL or YEp112SpGAL-WRN, or sgs1 top3/ YEp112SpGAL-SGS1 was treated as described above.
Genetic analysis of the slow growth phenotype in WRN transformed sgs1 top3 strain. To examine the effect of WRN expression on the growth of wild-type parental (W303-1A), sgs1, or sgs1 top3 strains, the corresponding strains transformed with YEp112SpGAL or YEp112SpGAL-WRN were streaked onto SC minus Trp plates containing either glu or gal as indicated. As a control, sgs1 top3/YEp112SpGAL-SGS1 was included. Plates were incubated at 30°C. To determine the ability of WRN to affect growth rate of sgs1 top3 strain at lower WRN protein expression levels, the sgs1 top3 strain transformed with YEp112SpGAL, YEp112SpGAL-WRN, or YEp112SpGAL-SGS1 was streaked onto SC minus Trp plates containing varying concentrations of gal as indicated.
To assess the functional requirements of WRN to restore the slow growth phenotype in the sgs1 top3 background, sgs1 top3 transformed with YEp112SpGAL-WRN (E84A, K577M, R834C, and K1016A) were streaked onto SC minus Trp plates containing either glu or gal as indicated. For controls, sgs1 top3 strain transformed with YEp112SpGAL, YEp112SpGAL-WRN or YEp112Sp GAL-SGS1 was included.
To evaluate the growth of transformed sgs1 top3 strains in liquid culture, yeast cells were grown in SC raf minus Trp at 30oC. Cultures were reinoculated in SC raf minus Trp and grown at 30°C to early log phase (A 600 of ~0.5). Cultures were then reinnoculated at OD0.05 in media containing 2% gal and their growth was followed by measuring absorbance at the indicated time intervals.
Cell cycle distribution of WRN transformed sgs1 top3 strain. Logarithmically growing cultures of sgs1 top3 transformed with YEp112SpGAL, YEp112SpGAL-WRN, or YEp112SpGAL-SGS1, and the vector-transformed wild-type parental strain were induced at 2% gal concentration for 6 h. For DAPI (4', 6-diamidino-2-phenylindole) staining, 70% ethanolfixed cells were washed with phosphate-buffered saline (PBS), stained and mounted in Vectashield mounting medium with DAPI (1 μg/ml) (Vector,USA). Cells were examined with an Axiovert 200 M microscope(Zeiss; 100x lens) and composite differential interference contrast(DIC) and fluorescence images were analyzed using AxioVision,version 3.0 program (Zeiss).
Western blot analyses. Transformed sgs1 or sgs1 top3 strains were grown in SC raf minus Trp at 30oC to an OD600 of 0.5. Cultures were then induced at the indicated gal concentration for 6 h. Cells (3 ml) were collected by centrifugation, washed with PBS, lysed in alkaline lysis buffer [50 mM NaOH, pH 10.5, 2 mM EDTA, 1 mM phenylmethylsulfonyl fluoride (PMSF), 2% SDS, 10% glycerol, 5% 2-mercaptoethanol and protease inhibitors (Roche Molecular Biochemicals)], boiled for 5 min, clarified by centrifugation, and neutralized with 1 M HCl. Proteins from equivalent amounts of cell lysate were resolved on 8-16% polyacrylamide SDS gels. Expression of WRN or WRN mutant proteins was determined by Western blot using a WRN mouse monoclonal antibody directed against an epitope in a purified C-terminal fragment of WRN [47] (1:1000, Spring Valley Labs). For quantitative Western blot analysis, increasing concentrations of purified recombinant His-tagged full-length WRN protein were included on gels with yeast lysate samples.
Supplementary Materials
WRN fails to rescue the MMS and HU sensitivity of <i>sgs1</i>. Cultures of wild-type parental strain (W303-1A) or sgs1 strain transformed with YEp112SpGAL or YEp112SpGAL-WRN were grown to early log phase (OD 600 of ~0.6 to 0.8). Ten-fold serial dilutions of these cultures were spotted onto SC-Trp plates containing 0.5% gal and either MMS or HU at the indicated concentrations. Plates were incubated at 30°C for 3 days (control plates) and 5 days (MMS or HU plates) and then photographed.
WRN expression has no effect on the growth rate of wild type parental strain W303-1A. Wild type parental strain W303-1A transformed with YEp112SpGAL, YEp112SpGAL-WRN, exonuclease-dead (YEp195SpGAL-WRN E84A), ATPase/helicase-dead (YEp195SpGAL-WRN K577M), RQC mutant (YEp195SpGAL-WRN K1016A) and polymorphic mutant (YEp195SpGAL-WRN R834C) was streaked on SC-Trp plate containg either 2% glu (Panel B) or galactose at varying concentrations as indicated (Panel C-G). Plates were incubated at 30°C for 2 days and then photographed. Composition of the plates was as in Panel A.
WRN expression has no effect on the growth rate of <i>sgs1</i> strain. sgs1 strain transformed with YEp112SpGAL, YEp112SpGAL-WRN, exonuclease-dead (YEp195SpGAL-WRN E84A), ATPase/helicase-dead (YEp195SpGAL-WRN K577M), RQC mutant (YEp195SpGAL-WRN K1016A) and polymorphic mutant (YEp195SpGAL-WRN R834C) was streaked on SC-Trp plate containing either 2% glu (Panel B) or gal at varying concentrations as indicated (Panel C-G). Plates were incubated at 30°C for 4 days and then photographed. Composition of the plates was as in Panel A.
Effect of WRN expression on the MMS and HU sensitivity of wild-type parental strain W303-1A. Logarithmically growing cultures wild type parental strain transformed with YEp112SpGAL or YEp112SpGAL-WRN was spotted in a ten-fold serial dilutions onto SC-Trp plates containing glu or gal and either MMS or HU at the indicated concentrations. Plates were incubated at 30°C for 2 days.
Oligonucleotides used for WRN site-directed mutagenesis.
Acknowledgments
This work was supported in full by the Intramural Research program of the NIH, National Institute on Aging. We thank Dr. Rodney Rothstein (Columbia University) for the yeast strains and Dr. Brad Johnson (University of Pennsylvania School of Medicine, Philadelphia, Pennsylvania) for the SGS1 expression plasmid. We thank Dr. Jian Lu (Laboratory of Molecular Gerontology, NIA-NIH) for helpful comments on the manuscript.
Conflicts of Interest
The authors in this manuscript have no conflict of interests to declare.
References
- 1. Prince PR , Emond MJ and Monnat RJ Jr. Loss of Werner syndrome protein function promotes aberrant mitotic recombination. Genes Dev. 2001; 15: 933 -938. [PubMed] .
- 2. Saintigny Y , Makienko K , Swanson C , Emond MJ and Monnat RJ Jr. Homologous recombination resolution defect in Werner syndrome. Mol Cell Biol. 2002; 22: 6971 -6978. [PubMed] .
- 3. Brosh RM Jr and Bohr VA. Human premature aging, DNA repair and RecQ helicases. Nucleic Acids Res. 2007; 35: 7527 -7544. [PubMed] .
- 4. Sharma S , Doherty KM and Brosh RM Jr. Mechanisms of RecQ helicases in pathways of DNA metabolism and maintenance of genomic stability. Biochem J. 2006; 398: 319 -337. [PubMed] .
- 5. Gangloff S , McDonald JP , Bendixen C , Arthur L and Rothstein R. The yeast type I topoisomerase Top3 interacts with Sgs1, a DNA helicase homolog: a potential eukaryotic reverse gyrase. Mol Cell Biol. 1994; 14: 8391 -8398. [PubMed] .
- 6. Shor E , Gangloff S , Wagner M , Weinstein J , Price G and Rothstein R. Mutations in homologous recombination genes rescue top3 slow growth in Saccharomyces cerevisiae. Genetics. 2002; 162: 647 -662. [PubMed] .
- 7. Bennett RJ and Wang JC. Association of yeast DNA topoisomerase III and Sgs1 DNA helicase: studies of fusion proteins. Proc Natl Acad Sci U S A. 2001; 98: 11108 -11113. [PubMed] .
- 8. Fricke WM , Kaliraman V and Brill SJ. Mapping the DNA topoisomerase III binding domain of the Sgs1 DNA helicase. J Biol Chem. 2001; 276: 8848 -8855. [PubMed] .
- 9. Ira G , Malkova A , Liberi G , Foiani M and Haber JE. Srs2 and Sgs1-Top3 suppress crossovers during double-strand break repair in yeast. Cell. 2003; 115: 401 -411. [PubMed] .
- 10. Mankouri HW and Hickson ID. Understanding the roles of RecQ helicases in the maintenance of genome integrity and suppression of tumorigenesis. Biochem Soc Trans. 2004; 32: 957 -958. [PubMed] .
- 11. Ahn JS , Osman F and Whitby MC. Replication fork blockage by RTS1 at an ectopic site promotes recombination in fission yeast. EMBO J. 2005; 24: 2011 -2023. [PubMed] .
- 12. Harmon FG , DiGate RJ and Kowalczykowski SC. RecQ helicase and topoisomerase III comprise a novel DNA strand passage function: a conserved mechanism for control of DNA recombination. Mol Cell. 1999; 3: 611 -620. [PubMed] .
- 13. Harmon FG , Brockman JP and Kowalczykowski SC. RecQ helicase stimulates both DNA catenation and changes in DNA topology by topoisomerase III. J Biol Chem. 2003; 278: 42668 -42678. [PubMed] .
- 14. Hartung F , Suer S , Knoll A , Wurz-Wildersinn R and Puchta H. Topoisomerase 3alpha and RMI1 suppress somatic crossovers and are essential for resolution of meiotic recombination intermediates in Arabidopsis thaliana. PLoS Genet. 2008; 4: e1000285 [PubMed] .
- 15. Win TZ , Mankouri HW , Hickson ID and Wang SW. A role for the fission yeast Rqh1 helicase in chromosome segregation. J Cell Sci. 2005; 118: 5777 -5784. [PubMed] .
- 16. Wu L and Hickson ID. The Bloom's syndrome helicase suppresses crossing over during homologous recombination. Nature. 2003; 426: 870 -874. [PubMed] .
- 17. Raynard S , Bussen W and Sung P. A double Holliday Junction dissolvasome comprising BLM, Topoisomerase IIIa and BLAP75. J Biol Chem. 2006; 281: 13861 -13864. [PubMed] .
- 18. Wu L , Bachrati CZ , Ou J , Xu C , Yin J , Chang M , Wang W , Li L , Brown GW and Hickson ID. BLAP75/RMI1 promotes the BLM-dependent dissolution of homologous recombination intermediates. Proc Natl Acad Sci USA. 2006; 103: 4068 -4073. [PubMed] .
- 19. Wu L , Chan KL , Ralf C , Bernstein DA , Garcia PL , Bohr VA , Vindigni A , Janscak P , Keck JL and Hickson ID. The HRDC domain of BLM is required for the dissolution of double Holliday junctions. EMBO J. 2005; 24: 2679 -2687. [PubMed] .
- 20. Bussen W , Raynard S , Busygina V , Singh AK and Sung P. Holliday junction processing activity of the BLM-Topo IIIalpha-BLAP75 complex. J Biol Chem. 2007; 282: 31484 -31492. [PubMed] .
- 21. Singh TR , Ali AM , Busygina V , Raynard S , Fan Q , Du CH , Andreassen PR , Sung P and Meetei AR. BLAP18/RMI2, a novel OB-fold-containing protein, is an essential component of the Bloom helicase-double Holliday junction dissolvasome. Genes Dev. 2008; 22: 2856 -2868. [PubMed] .
- 22. Xu D , Guo R , Sobeck A , Bachrati CZ , Yang J , Enomoto T , Brown GW , Hoatlin ME , Hickson ID and Wang W. RMI, a new OB-fold complex essential for Bloom syndrome protein to maintain genome stability. Genes Dev. 2008; 22: 2843 -2855. [PubMed] .
- 23. Johnson FB , Lombard DB , Neff NF , Mastrangelo MA , Dewolf W , Ellis NA , Marciniak RA , Yin Y , Jaenisch R and Guarente L. Association of the Bloom syndrome protein with topoisomerase IIIa in somatic and meiotic cells. Cancer Res. 2000; 60: 1162 -1167. [PubMed] .
- 24. Shimamoto A , Nishikawa K , Kitao S and Furuichi Y. Human RecQ5b, a large isomer of RecQ5 DNA helicase, localizes in the nucleoplasm and interacts with topoisomerases 3a and 3b. Nucleic Acids Res. 2000; 28: 1647 -1655. [PubMed] .
- 25. Hu Y , Lu X , Barnes E , Yan M , Lou H and Luo G. Recql5 and Blm RecQ DNA helicases have nonredundant roles in suppressing crossovers. Mol Cell Biol. 2005; 25: 3431 -3442. [PubMed] .
- 26. Sharma S , Stumpo DJ , Balajee AS , Bock CB , Lansdorp PM and Brosh RM Jr. , Blackshear PJ. RECQL, a member of the RecQ family of DNA helicases, suppresses chromosomal instability. Mol Cell Biol. 2007; 27: 1784 -1794. [PubMed] .
- 27. Sharma S and Brosh RM Jr. Human RECQ1 is a DNA damage responsive protein required for genotoxic stress resistance and suppression of sister chromatid exchanges. PLoS ONE. 2007; 2: e1297 [PubMed] .
- 28. Sharma S and Brosh RM Jr. Unique and important consequences of RECQ1 deficiency in mammalian cells. Cell Cycle. 2008; 7: 989 -1000. [PubMed] .
- 29. Fukuchi K , Martin GM and Monnat RJ Jr. Mutator phenotype of Werner syndrome is characterized by extensive deletions. Proc Natl Acad Sci U S A. 1989; 86: 5893 -5897. [PubMed] .
- 30. Kudlow BA , Kennedy BK and Monnat RJ Jr. Werner and Hutchinson-Gilford progeria syndromes: mechanistic basis of human progeroid diseases. Nat Rev Mol Cell Biol. 2007; 8: 394 -404. [PubMed] .
- 31. Sharma S , Sommers JA and Brosh RM Jr. In vivo function of the conserved non-catalytic domain of Werner syndrome helicase in DNA replication. Hum Mol Genet. 2004; 13: 2247 -2261. [PubMed] .
- 32. Kawabe T , Tsuyama N , Kitao S , Nishikawa K , Shimamoto A , Shiratori M , Matsumoto T , Anno K , Sato T , Mitsui Y , Seki M , Enomoto T , Goto M , Ellis NA , Ide T , Furuichi Y and Sugimoto M. Differential regulation of human RecQ family helicases in cell transformation and cell cycle. Oncogene. 2000; 19: 4764 -4772. [PubMed] .
- 33. Moser MJ , Kamath-Loeb AS , Jacob JE , Bennett SE , Oshima J and Monnat RJ Jr. WRN helicase expression in Werner syndrome cell lines. Nucleic Acids Res. 2000; 28: 648 -654. [PubMed] .
- 34. Brosh RM Jr , Orren DK, Nehlin JO, Ravn PH, Kenny MK, Machwe A, Bohr VA. Functional and physical interaction between WRN helicase and human Replication Protein A. J Biol Chem. 1999; 274: 18341 -18350. [PubMed] .
- 35. Huang S , Li B , Gray MD , Oshima J , Mian IS and Campisi J. The premature ageing syndrome protein, WRN, is a 3'-->5' exonuclease. Nat Genet. 1998; 20: 114 -116. [PubMed] .
- 36. Lee JW , Kusumoto R , Doherty KM , Lin GX , Zeng W , Cheng WH , von Kobbe C , Brosh RM Jr , Hu JS and Bohr VA. Modulation of Werner syndrome protein function by a single mutation in the conserved RecQ domain. J Biol Chem. 2005; 280: 39627 -39636. [PubMed] .
- 37. Kamath-Loeb AS , Welcsh P , Waite M , Adman ET and Loeb LA. The enzymatic activities of the Werner syndrome protein are disabled by the amino acid polymorphism R834C. J Biol Chem. 2004; 279: 55499 -55505. [PubMed] .
- 38. Mullen JR , Kaliraman V and Brill SJ. Bipartite structure of the SGS1 DNA helicase in Saccharomyces cerevisiae. Genetics. 2000; 154: 1101 -1114. [PubMed] .
- 39. Weinstein J and Rothstein R. The genetic consequences of ablating helicase activity and the Top3 interaction domain of Sgs1. DNA Repair (Amst). 2008; 7: 558 -571. [PubMed] .
- 40. Yamagata K , Kato J , Shimamoto A , Goto M , Furuichi Y and Ikeda H. Bloom's and Werner's syndrome genes suppress hyperrecombination in yeast sgs1 mutant: implication for genomic instability in human diseases. Proc Natl Acad Sci USA. 1998; 95: 8733 -8738. [PubMed] .
- 41. Heo SJ , Tatebayashi K , Ohsugi I , Shimamoto A , Furuichi Y and Ikeda H. Bloom's syndrome gene suppresses premature ageing caused by Sgs1 deficiency in yeast. Genes Cells. 1999; 4: 619 -625. [PubMed] .
- 42. Sharma S , Sommers JA and Brosh RM Jr. Processing of DNA replication and repair intermediates by the concerted action of RecQ helicases and Rad2 structure-specific nucleases. Protein Pept Lett. 2008; 15: 89 -102. [PubMed] .
- 43. Laine JP , Opresko PL , Indig FE , Harrigan JA , von Kobbe C and Bohr VA. Werner protein stimulates topoisomerase I DNA relaxation activity. Cancer Res. 2003; 63: 7136 -7146. [PubMed] .
- 44. Sung P and Klein H. Mechanism of homologous recombination: mediators and helicases take on regulatory functions. Nat Rev Mol Cell Biol. 2006; 7: 739 -750. [PubMed] .
- 45. Clark AB , Cook ME , Tran HT , Gordenin DA , Resnick MA and Kunkel TA. Functional analysis of human MutSa and MutSb complexes in yeast. Nucleic Acids Res. 1999; 27: 736 -742. [PubMed] .
- 46. Gietz RD , Schiestl RH , Willems AR and Woods RA. Studies on the transformation of intact yeast cells by the LiAc/SS-DNA/PEG procedure. Yeast. 1995; 11: 355 -360. [PubMed] .
- 47. von Kobbe C , Thoma NH , Czyzewski BK , Pavletich NP and Bohr VA. Werner syndrome pretein contains three structure specific DNA binding domains. J Biol Chem. 2003; 52997 -53006. [PubMed] .



